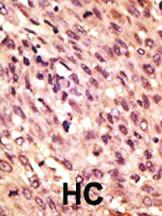

Antibody Lrp5 C-Term ,Each
$ 735.26
|
|
Details:
LRP5 C-TERM ANTIBODY 0.1MG^ This antibody is generated from rabbits immunized with a KLH conjugated synthetic peptide selected within aa 1550-1600 of human LRP5. Specificity: H, M. Concentration: 0.25 mg/ml. Size: 0.1 mg.
Additional Information
| SKU | 2204510 |
|---|---|
| UOM | EACH |
| UNSPSC | 12352203 |
| Manufacturer Part Number | AP6157A |
| Product Dimensions | 1X1X1 Inches |
| Product Weight | 0.1 |
